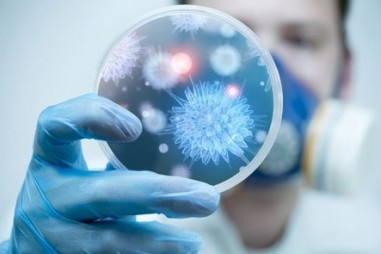
Xác nhận giá trị sử dụng phương pháp thử trong phân tích vi sinh

- KẾT QUẢ TÌM KIẾM CHO TỪ KHÓA "gia tri"


Xác nhận giá trị sử dụng phương pháp thử trong phân tích hóa học

AoV tham gia Triển lãm Thiết bị và Công nghệ Vinalab-Jaima 2023
TNNN - Tại Triển lãm Thiết bị và Công nghệ Vinalab-Jaima 2023 diễn ra ngày 10/2, Công ty TNHH Đảm bảo Chất lượng Việt Nam (AoV) có một gian trưng...

Chuyển hóa lưu huỳnh trong nước thải thành các vật liệu có giá trị
TNNN - Một nghiên cứu mới của ĐH Stanford trên tạp chí ACS ES&T Engineering đã mở đường cho việc khai thác nước thải để thu hồi các vật liệu có thể...

Giá trị dinh dưỡng của thực phẩm cân bằng bất chấp các mục tiêu về calo, muối và đường
TNNN - Cho thấy các chính sách cải cách tự nguyện nhằm cải thiện giá trị dinh dưỡng của thực phẩm không hiệu quả

Đổi mới công nghệ để tạo ra các sản phẩm có chất lượng và giá trị gia tăng cao
TNNN – Đây là nội dung Quyết định số 118/QĐ-TTg của Thủ tướng Chính phủ về Chương trình đổi mới công nghệ quốc gia đến năm 2030.

Biến carbon monoxide thành nhiên liệu lỏng có giá trị
TNNN - Các kỹ sư của Đại học Rice đang biến carbon monoxide trực tiếp thành axit axetic - tác nhân hóa học được sử dụng rộng rãi giúp giấm có mùi...

Xác nhận giá trị sử dụng phương pháp thử trong phân tích vi sinh

Xác nhận giá trị sử dụng phương pháp thử trong phân tích hóa học

Công nghệ mới biến rác thải nhựa thành nguyên liệu thô giá trị cao
TNNN - Khi chất dẻo trở thành đa dạng hóa, dễ dàng sản xuất, hành tinh hiện đang tập trung khoảng 8,3 tỷ tấn vật liệu nhựa được sản xuất nhưng không...

Sản xuất thử nghiệm thu hồi oxit vonfram trong quá trình xử lý quặng thiếc
TNNN - Dự án làm tăng hiệu quả sản xuất thiếc, giảm chi phí tiêu hao điện cho luyện thiếc trong lò điện hồ quang, tăng thực thu thiếc.

Phương pháp mới biến chất thải thành khoáng chất quan trọng có giá trị
TNNN - Quy trình mới xử lý thoát nước mỏ axit cho phép các nhà nghiên cứu thu hồi nồng độ nguyên tố đất hiếm cao hơn bằng cách sử dụng lượng hóa chất...

Khoa học và công nghệ là đòn bẩy tạo sức bật cho sản xuất nông nghiệp
TNNN - Trên cơ sở kết quả đạt được, hai Bộ sẽ đưa ra những vấn đề cần được ưu tiên triển khai về hoạt động KH&CN trong năm 2021 và giai đoạn...

EVFTA thúc đẩy Việt Nam vào chuỗi giá trị toàn cầu
TNNN - Hiệp định Thương mại tự do EVFTA được kỳ vọng chính là nền tảng quan trọng cho mối quan hệ kinh tế giữa Việt Nam và các nước EU.

Xác nhận giá trị sử dụng phương pháp thử trong phân tích hóa học

Hướng dẫn áp dụng các phương pháp phân tích vi sinh và xác nhận giá trị sử dụng của phương pháp

Xác nhận giá trị sử dụng phương pháp thử trong phân tích vi sinh

Xác nhận giá trị sử dụng phương pháp thử trong phân tích hóa học

Xác nhận giá trị sử dụng phương pháp thử trong phân tích hóa học
Xác nhận giá trị sử dụng phương pháp thử trong phân tích vi sinh

Phát huy giá trị nền tảng, tạo thế và lực mới để phát triển
TNNN - Trong công cuộc đẩy mạnh công nghiệp hóa, hiện đại hóa và hội nhập quốc tế ngày càng sâu rộng, Việt Nam cần phát huy giá trị nền tảng, tạo thế...

Dự án FIRST góp phần kết nối, lan tỏa và thúc đẩy đổi mới sáng tạo
TNNN - Sau 6 năm vận hành, dự án FIRST đã góp phần tích cực trong việc kết nối, lan tỏa và thúc đẩy đổi mới sáng tạo.






